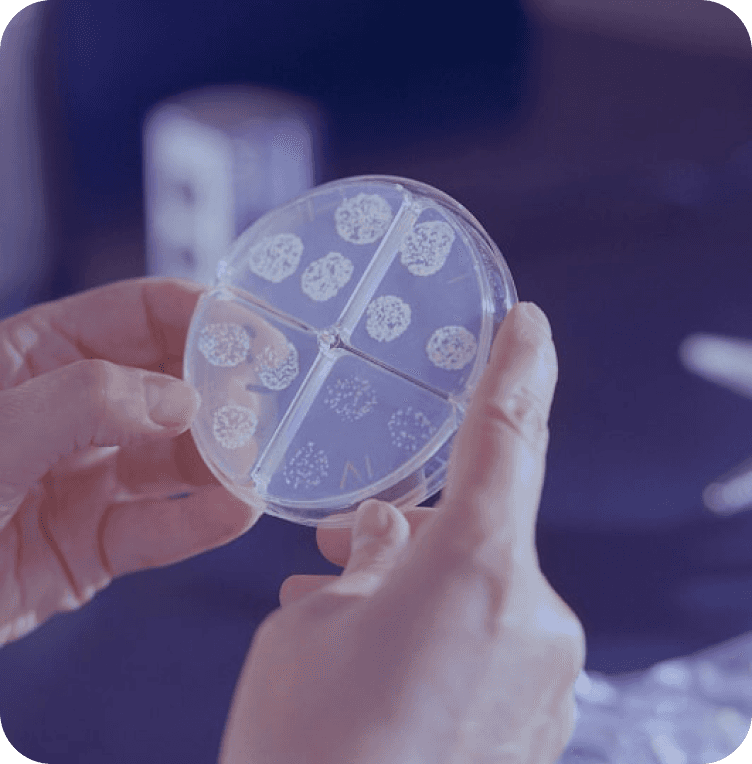

Our vision is to transform how we treat age-related diseases — not by targeting isolated symptoms, but by addressing the underlying biology that drives them.
Refoxy’s discovery platform focuses on FOXO3, a transcription factor that orchestrates the body’s natural defense mechanisms against stress, damage, and aging. By developing small molecules that selectively activate FOXO3, we aim to restore balance across multiple systems, with the potential to treat fibrosis, cardiovascular diseases, and other conditions.
To support this work, we have developed a proprietary discovery platform called F.act finder (FOXO Activator Finder), which helps us identify, validate, and optimize compounds with a focus on precision, safety, and therapeutic relevance.
Driving Innovation to Combat Age-Related Diseases
Cultivating values and a company culture to enable breaktrhough discoveries
Scientific Excellence
We are committed to rigorous research and cutting-edge innovation, ensuring our therapies meet the highest scientific and medical standards.
Integrity & Transparency
We embrace bold ideas and pioneering approaches to unlock new possibilities in longevity and age-related disease treatment.
Patient-Centered Impact
Every discovery we make is driven by the goal of improving lives. We prioritize patient well-being in all aspects of our work.